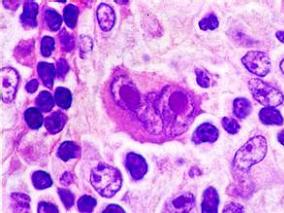
经典型霍奇金淋巴瘤：纳武单抗是未满足需求患者群体新的治疗选择

-
结直肠癌患者患糖尿病的风险多大?
环球医学资讯
2016年08月22日
点击量:367
1小时条评论已知糖尿病患者具有较高的结直肠癌风险,那将该问题颠倒,结直肠癌患者是否也有较高罹患糖尿病的风险呢?2016年2月,发表在《J Natl Cancer Inst》的一项研究表明,CRC患者比对照者诊断后第一年的糖尿病发生率高53%,在诊断后的第5年保持增加19%。 背景:已经很好的...
-
ALL儿童患者:氢化可的松加入到地塞米松治疗中能否…
环球医学资讯
2016年08月22日
点击量:356
1小时条评论众所周知,地塞米松因具有高效的抗白血病作用和中枢神经系统的渗透性而作为儿童急性淋巴细胞性白血病(ALL)治疗药物的重要组成部分。2016年7月,发表在《J Clin Oncol》的一项带有交叉设计的多中心、双盲、随机、对照试验表明,ALL儿童患者中,地塞米松治疗中加入生...
-
胰腺癌患者:诊断前循环代谢产物能否预测生存期?
环球医学资讯
2016年08月22日
点击量:143
1小时条评论胰腺癌是目前所有恶性肿瘤中预后最差的癌症,且诊断和治疗都很困难。胰腺癌会造成整个机体代谢的改变,那么其诊断前循环代谢产物能否预测生存期呢?2016年1月,发表在《J Natl Cancer Inst》的一项研究表明,TCA循环中间代谢产物的诊断前循环水平和遗传的ACO1基因型...
-
经典型霍奇金淋巴瘤:纳武单抗是未满足需求患者群体…
环球医学资讯
2016年08月22日
点击量:143
1小时条评论多种恶性肿瘤中报道了诸如纳武单抗等各种抗PD-1药物令人兴奋的结果。血液系统恶性肿瘤因其固有的免疫敏感性,是一理想的适宜进行免疫治疗的疾病。纳武单抗是治疗霍奇金淋巴瘤的一个选择吗?2016年7月,发表在《Lancet Oncol.》的一项单组2期研究表明,自体干细胞移植...
-
接受TKI治疗的CML患者血管事件风险或增加
环球医学资讯
2016年08月18日
点击量:209
1小时条评论酪氨酸激酶抑制剂(TKI)会急剧增加慢性粒细胞白血病(CML)患者的生存率,但是连续给药可引起长期毒性。2016年8月,发表在《Ann Intern Med》的一项研究调查了接受第一代和第二代TKI治疗的CML患者的血管事件发生率。结果表明,接受TKI治疗的CML患者可见动脉血管事件...
-
免疫介导性疾病:免疫抑制治疗 福兮?祸兮?
环球医学资讯
2016年08月16日
点击量:276
1小时条评论目前医学技术尚无法精确、完全地消灭转移癌细胞,而复发概率是由具体病情和治疗情况决定的。2016年7月发表在《Gastroenterology》的一项由美国和法国科学家进行的系统评价和Meta分析考察了免疫介导性疾病患者中,免疫抑制治疗后的癌症复发。 背景和目的:医生经常遇...
-
卵巢、输卵管或腹膜癌患者标准vs延长输注卡铂的过敏…
环球医学资讯
2016年08月16日
点击量:373
1小时条评论妇科恶性肿瘤患者多次行卡铂化疗易导致过敏反应。2016年7月发表在《Pharmacotherapy》的一项在美国开展的研究考察了卵巢、输卵管或腹膜癌患者预防性延长输注卡铂对过敏反应发生率的影响。 研究目的:旨在确定卵巢、输卵管或腹膜癌患者中,在约第8个累积卡铂周期时或...
-
贝伐珠单抗联合来曲唑能否改善晚期乳腺癌的生存期?
环球医学资讯
2008年12月16日
点击量:343
1小时条评论对于绝经后激素受体阳性转移性乳腺癌而言,肿瘤复发后筛选最合适的一线内分泌治疗方案至关重要。2016年8月,发表在《JCO》的III期CALGB 40503研究显示,联合贝伐珠单抗和来曲唑能改善激素受体阳性转移性乳腺癌的无进展生存期,但该获益与3~4级毒性风险的显著增加相...
-
GnRHa真的能保留淋巴瘤患者的生育能力吗?
环球医学资讯
2008年12月16日
点击量:228
1小时条评论GnRHa治疗保护卵巢功能似乎已成定论,然而,2016年8月,发表在《J Clin Oncol》的一项随访5年的研究显示,GnRHa对预防年轻淋巴瘤患者因化疗相关POF无效。该研究犹如扔下一枚重磅炸弹,引发如潮讨论。 目的:研究者先前报道了在随访1年后,促性腺激素释放激素激动剂...
-
哪些甲状腺癌患者TKI治疗期间咯血风险高?
环球医学资讯
2016年08月11日
点击量:306
1小时条评论抗血管生成酪氨酸激酶抑制剂(TKI)是晚期甲状腺癌(TC)治疗的基石,但TKI相关毒性引发担忧。2016年7月,发表在《J Clin Endocrinol Metab》的一项研究调查了TKI治疗甲状腺癌期间咯血的风险因素。 背景:抗血管生成酪氨酸激酶抑制剂(TKI)是晚期甲状腺癌(TC)治...

会员登录

